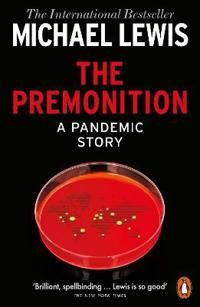
The Premonition | 0:e upplagan

The Premonition | 0:e upplagan
- Pocket, Engelska, 2022
- Författare: Michael Lewis
- Betyg:
177
kr
Skickas inom 6-8 vardagar
Butikslager
Onlinelager
I lager hos leverantör
Beskrivning
In January 2020, as people started dying from a new virus in Wuhan, China, few really understood the magnitude of what was happening. Except, that is, a small group of scientific misfits who in their different ways had been obsessed all their lives with how viruses spread and replicated - and with why the governments and the institutions that were supposed to look after us, kept making the same mistakes time and again.
This group saw what nobody else did. A pandemic was coming. We weren't prepared.
The Premonition is the extraordinary story of a group who anticipated, traced and hunted the coronavirus; who understood the need to think differently, to learn from history, to question everything; and to do all of this fast, in order to act, to save lives, communities, society itself. It's a story about the workings of the human mind; about the failures and triumphs of human judgement and imagination. It's the story of how we got to now.
Produktinformation
Kategori:
Ekonomi & management
Bandtyp:
Pocket
Språk:
Engelska
Förlag:
Penguin UK
Upplaga:
0
Utgiven:
2022-04-07
ISBN:
9780141996578
Sidantal:
336